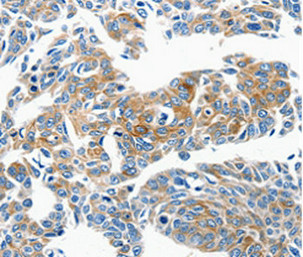

CCL23 Antibody
-
中文名稱:CCL23兔多克隆抗體
-
貨號(hào):CSB-PA784773
-
規(guī)格:¥2024
-
圖片:
-
其他:
產(chǎn)品詳情
-
產(chǎn)品名稱:Rabbit anti-Homo sapiens (Human) CCL23 Polyclonal antibody
-
Uniprot No.:
-
基因名:
-
宿主:Rabbit
-
反應(yīng)種屬:Human,Mouse,Rat
-
免疫原:Synthetic peptide corresponding to residues near the C terminal of Human C-C motif chemokine 6
-
免疫原種屬:Homo sapiens (Human)
-
克隆類型:Polyclonal
-
純化方式:Antigen Affinity Purified
-
濃度:It differs from different batches. Please contact us to confirm it.
-
產(chǎn)品提供形式:Liquid
-
應(yīng)用范圍:ELISA,IHC
-
推薦稀釋比:
Application Recommended Dilution IHC 1:50-1:100 -
Protocols:
-
儲(chǔ)存條件:Upon receipt, store at -20°C or -80°C. Avoid repeated freeze.
-
貨期:Basically, we can dispatch the products out in 1-3 working days after receiving your orders. Delivery time maybe differs from different purchasing way or location, please kindly consult your local distributors for specific delivery time.
-
用途:For Research Use Only. Not for use in diagnostic or therapeutic procedures.
相關(guān)產(chǎn)品
靶點(diǎn)詳情
-
功能:Shows chemotactic activity for monocytes, resting T-lymphocytes, and neutrophils, but not for activated lymphocytes. Inhibits proliferation of myeloid progenitor cells in colony formation assays. This protein can bind heparin. Binds CCR1. CCL23(19-99), CCL23(22-99), CCL23(27-99), CCL23(30-99) are more potent chemoattractants than the small-inducible cytokine A23.
-
基因功能參考文獻(xiàn):
- CCL23 is posttranslationally modified by trypsin-like serine proteases and CCL23(47-117) might be a major active form of CCL23 in nasal polyps with chronic rhinosinusitis. PMID: 26560043
- The coexistence of diabetes and oxidative stress independently affected CCL23 levels, while the presence of Cardiovascular disease and inflammation had no impact on its concentrations. PMID: 24995525
- ADAMTS 8, CCL23, and TNFSF15 are implicated in anti-angiogenic activities PMID: 24384427
- Data show CCL23 stimulates chemotaxis of human THP-1 monocytes and enhances release of MMP-2, and suggest it plays a role in atherogenesis. PMID: 21656154
- Overproduction of CCL23 in nasal polyps might contribute to the pathogenesis of eosinophilic chronic rhinosinusitis with nasal polyps PMID: 21497884
- Patients with systemic sclerosis who had elevated CCL23 levels had shorter disease duration, and a higher frequency of pulmonary arterial hypertension. Serum CCL23 level was increased in early phase of disease and could be a marker for disease activity. PMID: 20824279
- Fresh eosinophils contained trace amounts of CCL23 protein. CCL23 was significantly released into the supernatant when the eosinophils were stimulated with GM-CSF or IL-5 but not with IFN-gamma or immobilized sIgA. PMID: 21646793
- independently associated with coronary atherosclerosis PMID: 20187767
- CKbeta8 transduces the chemotaxis signal through the G(i)/G(o) protein, phospholipase C, protein kinase C delta and NF-kappaB. PMID: 19951712
- CCL23 promoted chemotactic migration and differentiation of endothelial cells, and neovascularization in the chick chorioallantoic membrane PMID: 15927850
- May play a direct role in angiogenesis via upregulation of matrix metalloproteinase (MMP)-2 expression. PMID: 16378600
- Collectively, these data suggest a link between the inducible phenotype of CCL23 expression in monocytes by the prototype Th2 molecule pair IL-4/STAT6 and the increased number of CCL23-expressing cells in skin of atopic dermatitis patients. PMID: 17371990
- A peptide ligand termed SHAAGtide is cleaved from CCL23; is itself an attractant of monocytes and neutrophils in vitro; recruits leukocytes in vivo; is more potent than other natural agents with activity for FPRL1; receives authors' designation "CCR12." PMID: 17513790
- This protein may participate in the malignant progression of certain human cancer cells that overexpress ErbB2 through the transactivation of ErbB2 tyrosine kinase. PMID: 18258606
- CCL23, M-CSF, TNFRSF9, TNF-alpha, and CXCL13 are predictive of rheumatoid arthritis disease activity and may be useful in the definition of disease subphenotypes and in the measurement of response to therapy in clinical studies. PMID: 18668547
- these findings suggest that CCL23 results in up-regulation of KDR/flk-1 receptor gene transcription and protein expression and that KDR/Flk-1 up-regulation induced by CCL23 may contribute to potentiation of VEGF action in angiogenesis. PMID: 19265684
顯示更多
收起更多
-
亞細(xì)胞定位:Secreted.
-
蛋白家族:Intercrine beta (chemokine CC) family
-
組織特異性:High levels in adult lung, liver, skeletal muscle and pancreas. Moderate levels in fetal liver, adult bone marrow and placenta. The short form is the major species and the longer form was detected only in very low abundance. CCL23(19-99), CCL23(22-99), CC
-
數(shù)據(jù)庫(kù)鏈接:
Most popular with customers
-
-
YWHAB Recombinant Monoclonal Antibody
Applications: ELISA, WB, IHC, IF, FC
Species Reactivity: Human, Mouse, Rat
-
Phospho-YAP1 (S127) Recombinant Monoclonal Antibody
Applications: ELISA, WB, IHC
Species Reactivity: Human
-
-
-
-
-